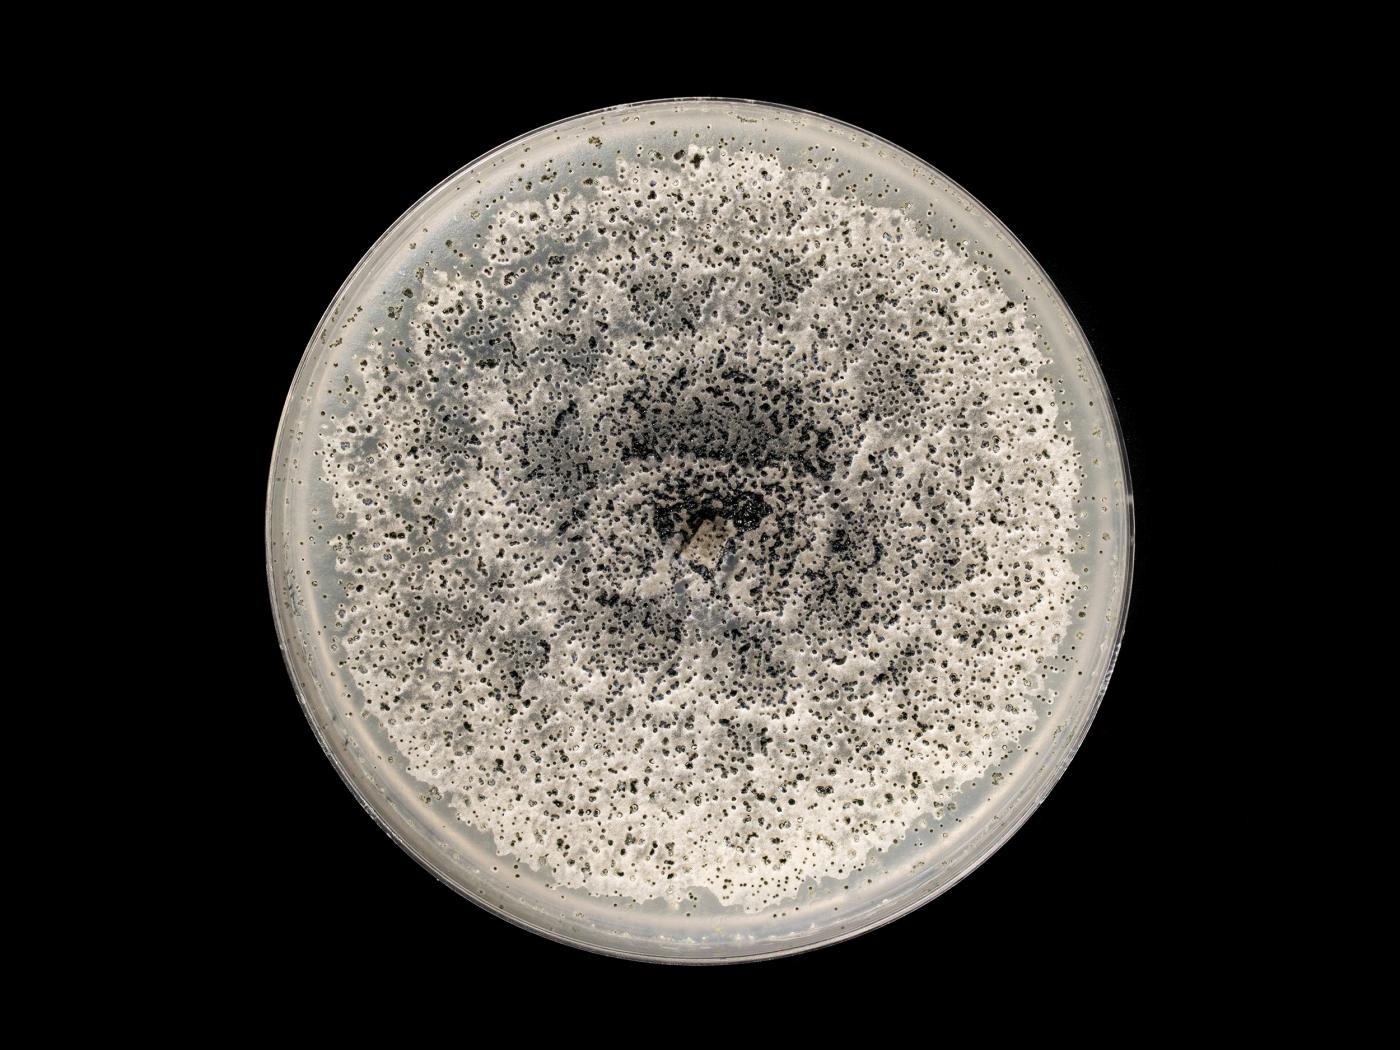

Nom latin :
Coniella diplodiella
Nom latin synonyme :
Coniothyrium diplodiella
Dommages
Le champignon Coniella diplodiella peut affecter la culture du raisin (vigne).
Cultures ou autres organismes affectés
Vigne (raisin)
/fr/maladies-parasitaires/champignons/coniella-diplodiella/vigne-raisin-pourriture-blanche
Vigne (raisin) - Pourriture blanche (Coniella diplodiella)_1
Vigne (raisin) - Pourriture blanche (Coniella diplodiella)_2
Vigne (raisin) - Pourriture blanche (Coniella diplodiella)_2